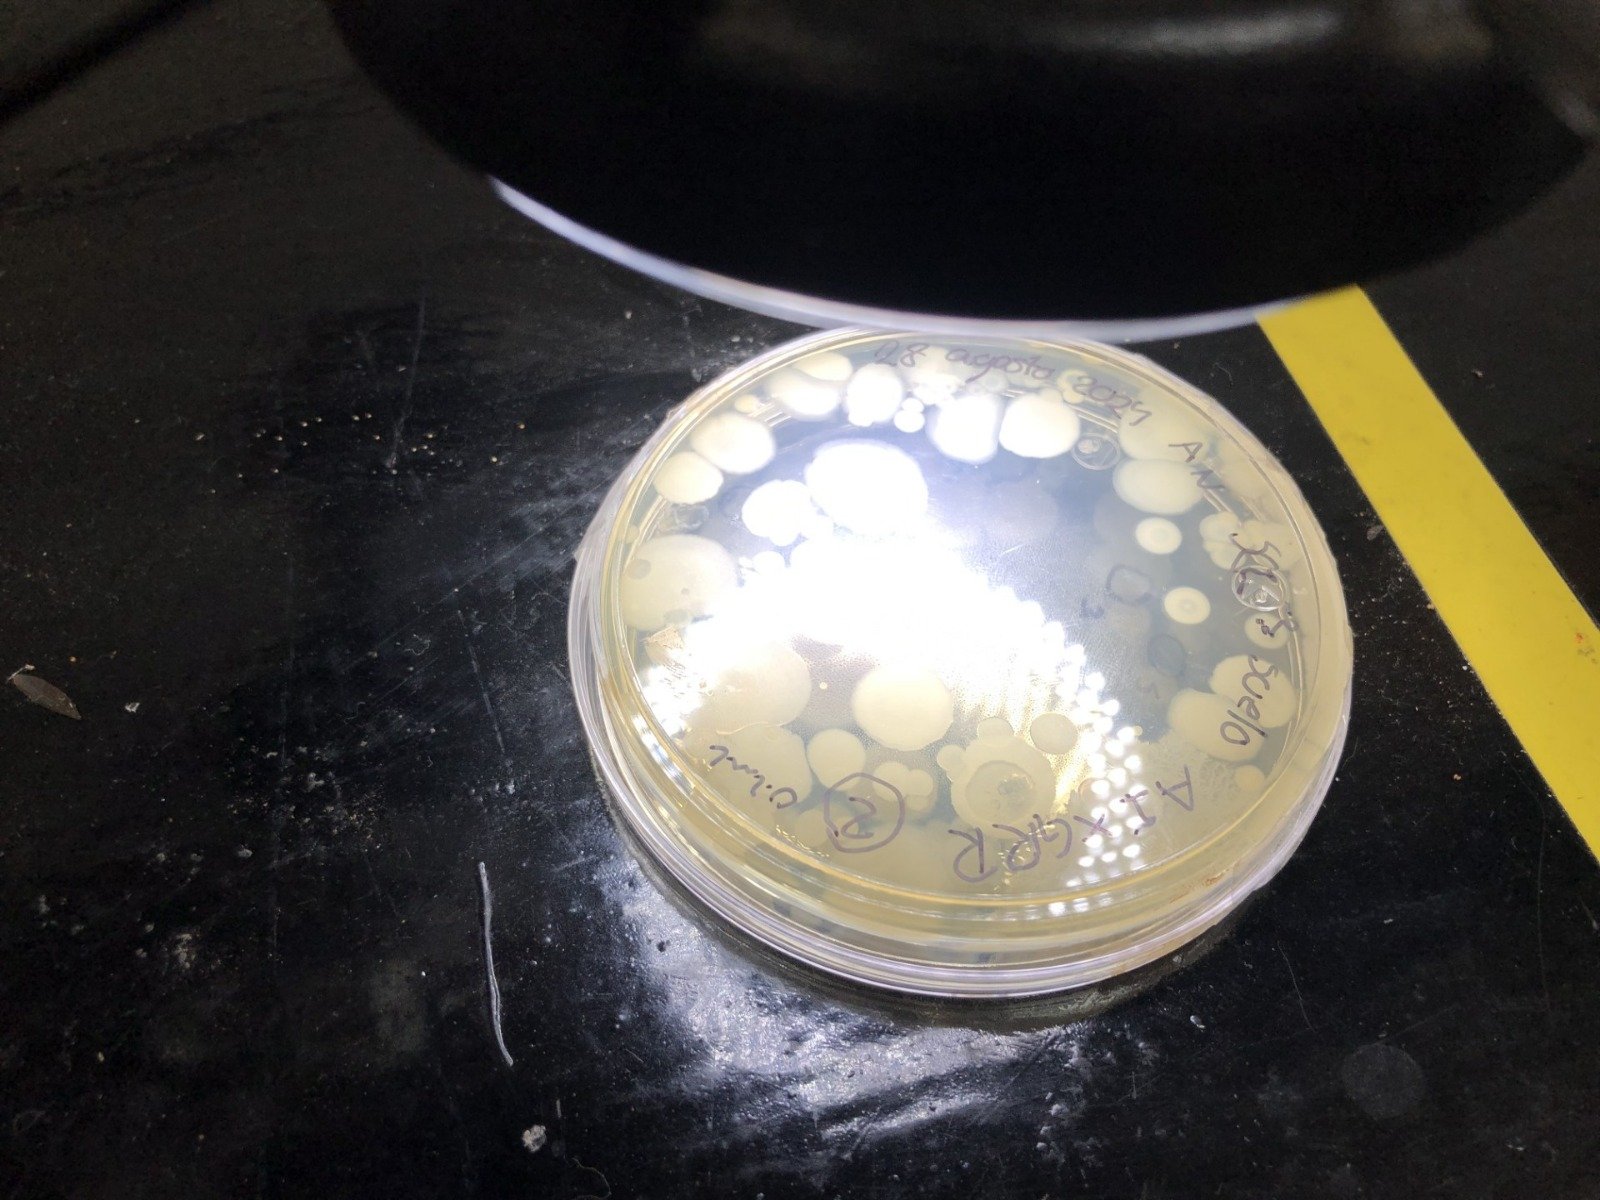

Agrobiotecnología UAQ aporta a la resolución de problemas en la producción del campo
- La Facultad de Química invita a estudiar esta ingeniería, la próxima convocatoria se publicará en diciembre de 2024, con inicio de clases en el periodo 2025-2.
Con el objetivo de atender la problemática agrícola actual y futura en México, vinculada a la satisfacción de la demanda de productos de calidad, la Facultad de Química (FQ) de la Universidad Autónoma de Querétaro (UAQ) reestructuró el plan académico de Ingeniería Agroquímica, logrando el cambio de nomenclatura a Ingeniería en Agrobiotecnología.
De acuerdo con el coordinador de la carrera, Mtro. Francisco Romero González, el objetivo de esta oferta educativa es formar expertas y expertos integrales con liderazgo, responsabilidad ética y sólidos conocimientos en las áreas de química, biotecnología, bioquímica, ingeniería agrícola, sanidad e inocuidad.
Asimismo, Romero González destacó que las y los estudiantes contribuyen de manera significativa a la resolución de los desafíos en este sector, ya que se involucran en la producción vegetal en diversos entornos tecnológicos, aplicando técnicas actuales con el fin de alimentar a la población y proteger las riquezas naturales.
Al egresar, las y los profesionistas podrán desempeñarse en laboratorios de análisis de fertilidad de suelos y calidad de agua, inocuidad microbiana de cosechas y sanidad vegetal; en invernaderos de producción intensiva de hortalizas; en la asesoría técnica para la nutrición de cultivos; en la industria agroquímica, vinícola y alimentaria; así como en el desarrollo de agronegocios y la propagación de especies vegetales.
El programa de Ingeniería en Agrobiotecnología tiene una duración total de 10 semestres y es de carácter anual. La próxima convocatoria se publicará en diciembre de 2024, con inicio de clases en el periodo 2025-2. Las personas interesadas en conocer más sobre esta oferta educativa de la FQ pueden acceder al siguiente enlace: https://quimica.uaq.mx/index.php/programas/licenciaturas/licenciaturas-2023/ingeniero-en-agrobiotecnologia.




